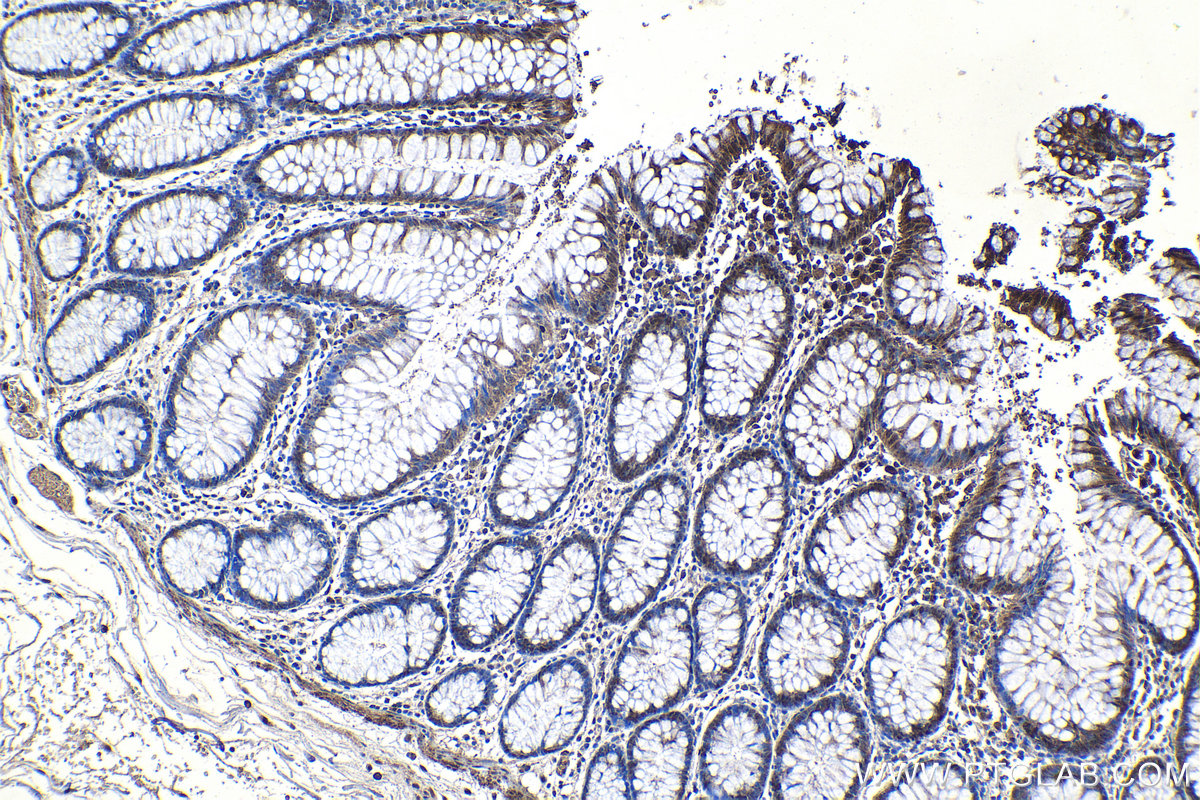

IHCeasy® SIRT1 Ready-To-Use IHC Kit
SIRT1 Ready-to-use reagent kit for IHC.
Reactivity
Human, Mouse, Rat
Sample Type
FFPE tissue
Cat no : KHC1207
Synonyms
hSIR2, hSIRT1, SIR2 like protein 1, SIR2L1, SIRT1
Validation Data Gallery
Product Information
KHC1207 is a ready-to-use IHC kit for staining of SIRT1. The kit provides all reagents, from antigen retrieval to cover slip mounting, that require little to no diluting or handling prior to use. Simply apply the reagents to your sample slide according to the protocol and you're steps away from obtaining high-quality IHC data.
| Product name | IHCeasy SIRT1 Ready-To-Use IHC Kit |
| Sample type | FFPE tissue |
| Assay type | Immunohistochemistry |
| Primary antibody type | Rabbit Polyclonal |
| Secondary antibody type | Polymer-HRP-Goat anti-Rabbit |
| Reactivity | Human, Mouse, Rat |
Kit components
| Component | Size | Concentration |
|---|---|---|
| Antigen Retrieval Buffer | 100 mL | 50× |
| Washing Buffer | 100 mL ×2 | 20× |
| Blocking Buffer | 5 mL | RTU |
| Primary Antibody | 5 mL | RTU |
| Secondary Antibody | 5 mL | RTU |
| Chromogen Component A | 0.2 mL | RTU |
| Chromogen Component B | 4 mL | RTU |
| Signal Enhancer | 5 mL | RTU |
| Counter Staining Reagent | 5 mL | RTU |
| Mounting Media | 5 mL | RTU |
| Datasheet | 1 Copy | |
| Manual | 1 Copy |
Background Information
SIRT1, also named as SIR2L1, contains a deacetylase sirtuin-type domain and belongs to the sirtuin family. SIRT1 may be found in nucleolus, nuclear euchromatin, heterochromatin and inner membrane. It can shuttles between nucleus and cytoplasm. SIRT1 regulates processes such as apoptosis and muscle differentiation by deacetylating key proteins. SIRT1 in particular initiates several signaling events relevant to cardioprotection, including: activation of endothelial nitric oxide synthase, INS receptor signaling, and autophagy. In addition SIRT1 activation elicits resistance to oxidative stress via regulation of transcription factors and co-activators such as FOXO, Hif-2a, and NF-kB. SIRT1 regulates the p53-dependent DNA damage response pathway by binding to and deacetylating p53, specifically at Lysine 382.
Properties
| Storage Instructions | All the reagents are stored at 2-8°C. The kit is stable for 6 months from the date of receipt. |
| Synonyms | hSIR2, hSIRT1, SIR2 like protein 1, SIR2L1, SIRT1 |